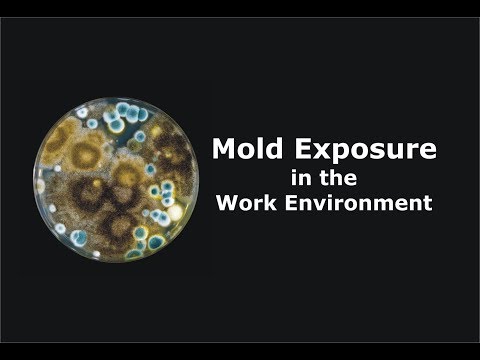

Recognizing Mold Exposure Issues in the Work Environment
Clark Seif Clark provides testing and consulting services to identify and resolve indoor environmental issues associated with mold and other contaminants.
While there are currently no federal standards for airborne concentrations of mold or mold spores in the work environment, the General Duty Clause of the Occupational Safety and Health Act of 1970 (OSH Act) does states that employers have the responsibility to provide a safe and healthful workplace that is free from serious recognized hazards.
Shortly after Hurricane Michael left a path of destruction across parts of the Florida Panhandle and neighboring areas, the Centers for Disease Control and Prevention (CDC) and the National Institute for Occupational Safety and Health (NIOSH) released a guidance document for residents and workers tasked with cleaning up and repairing damaged properties.
 
The document covers a number of potential health and safety issues that people could encounter. One particular area of concern is mold and specifically having it in the workplace. Unfortunately, mold exposure issues are not just associated with hurricane damaged areas. Any indoor work environment that has suffered water damage or elevated humidity levels resulting in mold amplification can present personnel with exposure to elevated indoor mold concentrations.
 
“While there are currently no federal standards for airborne concentrations of mold or mold spores in the work environment, the General Duty Clause of the Occupational Safety and Health Act of 1970 (OSH Act) does states that employers have the responsibility to provide a safe and healthful workplace that is free from serious recognized hazards,” said Derrick A. Denis, Vice President of Indoor Environmental Quality of Clark Seif Clark (CSC). “There are many government guidelines, such as the OSHA A Brief Guide to Mold in the Workplace, the EPA Mold Remediation in Schools and Commercial Buildings Guide and the NIOSH Recommendations for the Cleaning and Remediation of Flood-Contaminated HVAC Systems: A Guide for Building Owners and Managers. Additionally, there are abundant industry guidelines such as the IICRC S520 Standard and Reference Guide for Professional Mold Remediation and the AIHA Assessment, Remediation, and Post‐Remediation Verification of Mold in Building. Exposure to moldy environments may cause a mold overexposure that can result in adverse health effects in workers or other occupants. Restoration workers are at higher risk because they disturb and aerosolize the moldy materials in close proximity to their faces, they can come into direct skin contact with moldy materials and they may work with these materials for extended durations. If susceptible and overexposed, workers might experience allergic responses, sensitization, intoxication or even infection.  Protecting workers from mold related hazards is only one of many risks employers need to consider during flood responses, but with training, appropriate engineering controls and personal protective equipment, worker risks can be minimized.”
 
Employers and workers concerned about mold exposure can turn to CSC for indoor environmental assessments conducted by experienced professionals. Through building inspections, testing and monitoring, CSC can identify issues associated with mold, water damage and other indoor concerns. They also offer remediation oversight to help ensure any issues are correctly resolved. CSC has even sponsored an educational video about mold exposure and the work environment that can be seen at: https://youtu.be/hhjzdddTQ7o
 
To learn more about this or other indoor air quality, occupational, environmental, health and safety testing services, please visit www.csceng.com, email  csc@csceng.com  or call (800) 807-1118. 
 
 About Clark Seif Clark 
CSC was established in 1989 to help clients in both public and private sectors address indoor air quality, occupational, environmental, and health and safety (EH&S) issues. CSC is a leading provider of these services with multiple offices along the western seaboard and southwest. The company believes in science-based protocols and has a strong background in engineering, making them the preferred environmental consultants to industrial clients, healthcare facilities, architects, schools, builders, contractors, developers and real estate professionals.
 
( Press Release Image: https://photos.webwire.com/prmedia/12710/232199/232199-1.jpg )
WebWireID232199
- Contact Information
 - Paul Cochrane
 - President
 - Cochrane & Associates, LLC
 - Contact via E-mail
 
This news content may be integrated into any legitimate news gathering and publishing effort. Linking is permitted.
News Release Distribution and Press Release Distribution Services Provided by WebWire.